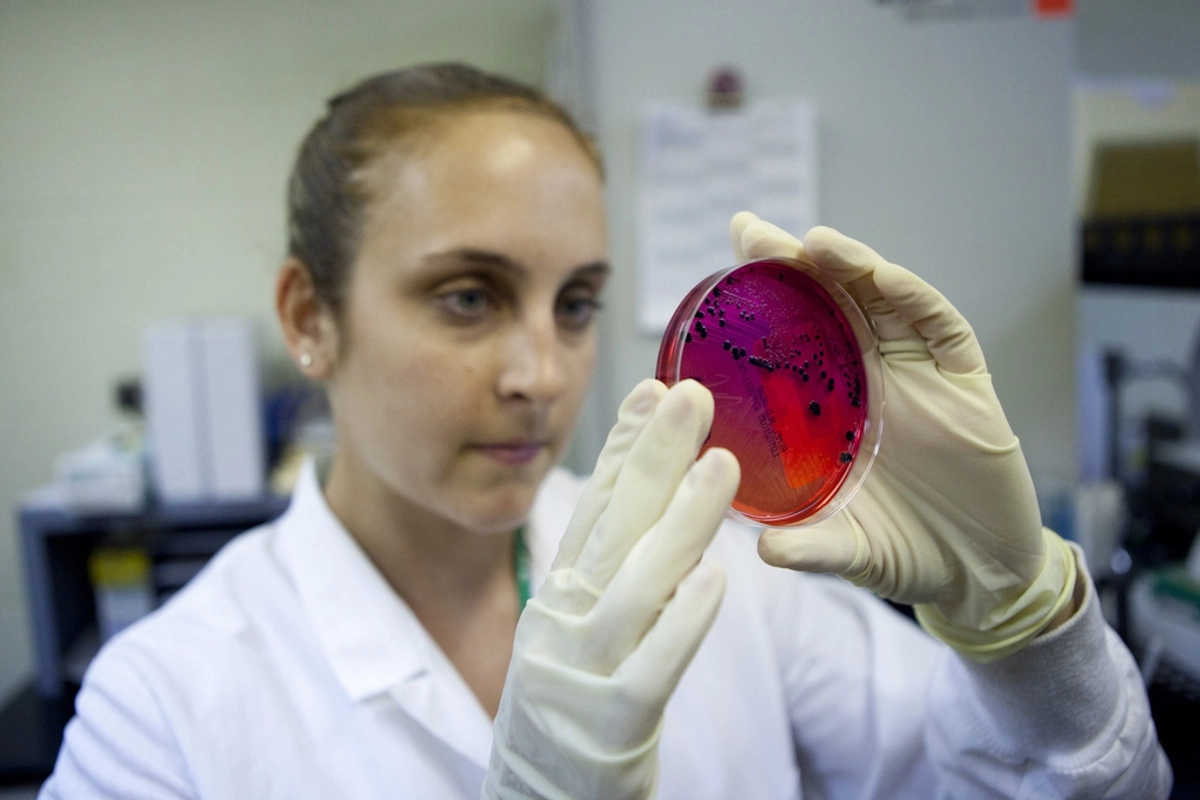

Российские туристы привезли сальмонеллез из 5-звездочного отеля в ОАЭ
- 18 мая 2018 19:46
- Георгий Самсонов, журналист «Ридуса»
Граждане России вернулись на родину с сальмонеллезом после отдыха в пятизвездочной гостинице Sheraton Sharyah Beach Resort & Spa, расположенной в Шардже (ОАЭ).
Туристы находились там в первой половине мая. В итоге 36 россиян, включая семь детей, обратились за медицинской помощью по поводу острого гастроэнтерита. Поскольку эта услуга была предусмотрена медицинской страховкой, ее туристам оказали.
По их возвращении в Казань они прошли лабораторные исследования, в результате которых была обнаружена сальмонелла, сообщает газета «Известия» со ссылкой на информацию Роспотребнадзора, полученную от Ассоциации туроператоров России.
В настоящее время проводятся необходимые профилактические мероприятия по предотвращению распространения заболевания.
Кроме того, в МИД РФ был направлен запрос с просьбой оказать содействие в получении информации о состоянии здоровья других туристов, а также о профилактических и лечебных мерах, проводимых властями ОАЭ.
Ранее сообщалось, что куриные яйца из Украины вызвали эпидемию сальмонеллеза в Израиле.
- Телеграм
- Дзен
- Подписывайтесь на наши каналы и первыми узнавайте о главных новостях и важнейших событиях дня.

Войти через социальные сети: